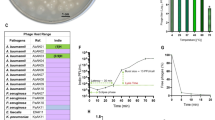

Abstract
We characterized two bacteriophages, ΦFG02 and ΦCO01, against clinical isolates of Acinetobacter baumannii and established that the bacterial capsule is the receptor for these phages. Phage-resistant mutants harboured loss-of-function mutations in genes responsible for capsule biosynthesis, resulting in capsule loss and disruption of phage adsorption. The phage-resistant strains were resensitized to human complement, beta-lactam antibiotics and alternative phages and exhibited diminished fitness in vivo. Using a mouse model of A. baumannii infection, we showed that phage therapy was effective.
This is a preview of subscription content, access via your institution
Access options
Access Nature and 54 other Nature Portfolio journals
Get Nature+, our best-value online-access subscription
$32.99 / 30 days
cancel any time
Subscribe to this journal
Receive 12 digital issues and online access to articles
$119.00 per year
only $9.92 per issue
Buy this article
- Purchase on SpringerLink
- Instant access to full article PDF
Prices may be subject to local taxes which are calculated during checkout


Similar content being viewed by others
Data availability
The genetic sequences acquired during this study have been deposited into the National Center for Biotechnology Information database as a BioProject under accession number PRJNA608808. The project contains data for A. baumannii strains AB900 (accession number SAMN14483301), A9844 (accession number SAMN14483302), ΦFG02-R AB900 (accession number SAMN14511297) and ΦCO01-R A9844 (accession number SAMN14511298). Phage genomes were independently submitted on GenBank (ΦFG02 accession number MT648818 and ΦCO01 accession number MT648819). Source data are provided with this paper.
Code availability
The study did not involve the creation of novel code for bioinformatics analyses. All the used software is freely accessible and is referenced in the Supplementary Information.
References
Antibiotic Resistance Threats in the United States (Centers for Disease Control and Prevention, 2019); https://www.cdc.gov/drugresistance/biggest-threats.html
Global Priority List of Antibiotic-Resistant Bacteria to Guide Research, Discovery, and Development of New Antibiotics (World Health Organization, 2017); https://www.who.int/medicines/publications/WHO-PPL-Short_Summary_25Feb-ET_NM_WHO.pdf?ua=1
Peleg, A. Y., Seifert, H. & Paterson, D. L. Acinetobacter baumannii: emergence of a successful pathogen. Clin. Microbiol. Rev. 21, 538–582 (2008).
Gordillo Altamirano, F. L. & Barr, J. J. Phage therapy in the postantibiotic era. Clin. Microbiol. Rev. 32, e00066-18 (2019).
Schooley, R. T. et al. Development and use of personalized bacteriophage-based therapeutic cocktails to treat a patient with a disseminated resistant Acinetobacter baumannii infection. Antimicrob. Agents Chemother. 61, e00954-17 (2017).
Ackermann, H.-W. in Advances in Virus Research Vol. 82 (eds M. Łobocka & W. T. Szybalski) 1–32 (Academic Press, 2012).
Kenyon, J. J. & Hall, R. M. Variation in the complex carbohydrate biosynthesis loci of Acinetobacter baumannii genomes. PLoS ONE 8, e62160 (2013).
Singh, J. K., Adams, F. G. & Brown, M. H. Diversity and function of capsular polysaccharide in Acinetobacter baumannii. Front. Microbiol. 9, 3301 (2019).
Morris, F. C., Dexter, C., Kostoulias, X., Uddin, M. I. & Peleg, A. Y. The mechanisms of disease caused by Acinetobacter baumannii. Front. Microbiol. 10, 1601 (2019).
Geisinger, E., Huo, W., Hernandez-Bird, J. & Isberg, R. R. Acinetobacter baumannii: envelope determinants that control drug resistance, virulence, and surface variability. Annu. Rev. Microbiol. 73, 481–506 (2019).
Torres-Barceló, C. & Hochberg, M. E. Evolutionary rationale for phages as complements of antibiotics. Trends Microbiol. 24, 249–256 (2016).
Chan, B. K. et al. Phage selection restores antibiotic sensitivity in MDR Pseudomonas aeruginosa. Sci. Rep. 6, 26717 (2016).
Russo, T. A. et al. The K1 capsular polysaccharide of Acinetobacter baumannii strain 307-0294 is a major virulence factor. Infec. Immun. 78, 3993–4000 (2010).
Bonilla, N. et al. Phage on tap—a quick and efficient protocol for the preparation of bacteriophage laboratory stocks. PeerJ 4, e2261 (2016).
Davison, E. & Colquhoun, W. Ultrathin formvar support films for transmission electron microscopy. J. Electron Microsc. Tech. 2, 35–43 (1985).
Gillis, A. & Mahillon, J. An improved method for rapid generation and screening of Bacillus thuringiensis phage-resistant mutants. J. Microbiol. Methods 106, 101–103 (2014).
Datsenko, K. A. & Wanner, B. L. One-step inactivation of chromosomal genes in Escherichia coli K-12 using PCR products. Proc. Natl Acad. Sci. USA 97, 6640–6645 (2000).
Wiegand, I., Hilpert, K. & Hancock, R. E. Agar and broth dilution methods to determine the minimal inhibitory concentration (MIC) of antimicrobial substances. Nat. Protoc. 3, 163–175 (2008).
Performance Standards for Antimicrobial Susceptibility Testing; Twenty-Fifth Informational Supplement Document M100-S25 (Clinical and Laboratory Standards Institute, 2015).
Acknowledgements
We thank L. Perlaza-Jiménez and R. Dunstan for expert advice in the early stage of this project; the Monash Ramaciotti Cryo-EM platform for the use of facilities; A. Fulcher and A. de Marco for granting access to the SEM; C. Vásconez for feedback regarding the readability, clarity and structure of the manuscript; and D. McCarthy for raw sewage samples for phage isolation. F.G.A. acknowledges the support from Monash University through the Monash Postgraduate Research Scholarships funding his doctoral studies. T.J.L. is an ARC Australian Laureate Fellow (FL130100038). This work, including the efforts of J.J.B., was funded by the Australian Research Council (ARC) Discovery Early Career Researcher Award (DECRA) (DE170100525), National Health and Medical Research Council (NHMRC: 1156588) and the Perpetual Trustees Australia award (2018HIG00007).
Author information
Authors and Affiliations
Contributions
F.G.A., T.J.L., A.Y.P. and J.J.B. conceived the study. F.G.A., M.T., C.O. and L.K. performed phage isolation. F.G.A. and D.S. performed phenotypic and genotypic characterization of phages. J.H.F., R.P. and F.C.M. planned and performed knockout and complementation experiments. D.K. performed TEM and SEM. S.K.A. performed bioinformatics analyses of bacterial genomes. F.G.A. performed most of the in vitro characterization of phage-resistant mutants, with help from J.H.F. (capsule, biofilm and antibiotic assays) and M.T. (biofilm assays). F.G.A. and X.K. performed in vivo experiments. M.K.O., T.J.L., A.Y.P. and J.J.B. provided resources for experimental work. T.J.L., A.Y.P. and J.J.B. supervised and funded the project. F.G.A. and J.J.B. wrote the original draft. All authors were involved in reviewing and editing the final manuscript.
Corresponding authors
Ethics declarations
Competing interests
The authors declare no competing interests.
Additional information
Peer review information Nature Microbiology thanks the anonymous reviewers for their contribution to the peer review of this work. Peer reviewer reports are available.
Publisher’s note Springer Nature remains neutral with regard to jurisdictional claims in published maps and institutional affiliations.
Extended data
Extended Data Fig. 1 Characterization of Acinetobacter baumannii-specific phages.
a, Host range of the eight A. baumannii-specific phages isolated in this study. Bacterial strains are ordered by the core-genome alignment phylogenetic tree on the left. Productive infection is defined as lysis on a spot assay and production of plaques on a soft agar overlay, whereas non-productive infection is defined as lysis on a spot assay with no plaques on a soft overlay agar. Efficiency of plating (EOP) is reported as a percentage compared to the host of isolation. b,c, Plaque morphology of phage øFG02 on host AB900 and øCO01 on host A9844, showing the central clearings or lysis zones surrounded by hazy halos. Scale bars: 1 cm. d,e, One-step killing curves of phages øFG02 and øCO01 on their hosts of isolation. Latency time was measured from the beginning of the experiment to when the curve at exponential growth reached the initial phage inoculum, whereas burst size was calculated by dividing the maximum free phage count after bacterial burst by the initial phage titer in the experiment. Data are mean ± s.e.m. (n = 3). f,g, Growth curves of A. baumannii strains AB900 and A9844 with and without phages. Phages were applied at two different multiplicities of infection (1 and 0.1). Lytic activity of phages is shown by the drop in optical density shortly after initiation of the bacterial exponential growth phase; and emergence of phage resistance is shown after 6 h of incubation. Data are mean ± s.d. (n = 3). OD600, optical density at 600 nm.
Extended Data Fig. 2 Reduced capsule and biofilm production in phage-resistant mutants.
a, Microscopic inspection of capsule thickness in slides stained using the Maneval’s technique. Scale bars: 10 μm. b, Standard curve for the phenol-chloroform capsule quantification assay, calibrated with carbohydrate standards ranging from 0 to 300 μg/ml. OD490, optical density at 490 nm. c, Production of capsule polysaccharides (n = 3), for AB900 vs. øFG02-R AB900: 79 ± 1.7 μg/ml vs. 35.6 ± 8.8 μg/ml (mean ± s.d.), P = 0.001; and for A9844 vs. øCO01-R A9844: 179.9 ± 15.6 μg/ml vs. 58.1 ± 5.6 μg/ml; P = 0.0002. d,e, Repeatability of phage-resistance evolution was assessed by measuring capsule production of twelve independently-evolved phage-resistant strains from each of the wild type hosts (AB900 and A9844). Violin plots (n = 3) of surface polysaccharides produced by each strain compared between the wild type host and each of the additional phage-resistant mutants. f,g, Biofilm production on a polystyrene surface at 48 h, measured by absorbance of crystal-violet stained and ethanol-solubilized biofilm (n = 3); optical density of biofilm 1 ± 0.1 vs. 0.5 ± 0.1 (mean ± s.d.), P = 0.0038, for AB900 vs. øFG02-R AB900; and 1.3 ± 0.2 vs. 0.4 ± 0.03, P = 0.001, for A9844 vs. øCO01-R A9844. For panels C, D, E and G, wild type strains represented in red and (original) phage-resistant mutants in blue, bars represent medians, each point represents the average from three technical replicates, and P values pertain to unpaired t tests, two-tailed. ** = P < 0.005; n.s. = non-significant.
Extended Data Fig. 3 Further resensitization of phage-resistant A. baumannii to antimicrobials.
a, Human serum killing assay. Freshly-thawed human serum was inoculated with 105 CFU ml–1 of A. baumannii, and the change in bacterial load was measured at regular intervals. Wild type strains (shades of red) grew in serum whereas phage-resistant strains (shades of blue) were rapidly killed. Data are mean ± s.e.m. (n = 3). b, Expanded phage host range map of the A. baumannii-specific phage library against øFG02-R AB900 and øCO01-R A9844 reveals sensitization to additional phages. Efficiency of plating (EOP) is reported as a percentage compared to the host of isolation.
Supplementary information
Supplementary Information
Supplementary Note 1: Background information. Supplementary Note 2: Characterization of A. baumannii-specific phages. Supplementary Note 3: Genetic analysis of phages ΦFG02 and ΦCO01. Supplementary Note 4: Reversion to wild type after in vivo experiments. Supplementary Note 5: Analysis of in vivo phage replication. Supplementary Note 6: Discussion. Supplementary Figure 1: Attempted production of A9844 lysogens. Supplementary Figure 2: Isolation of A. baumannii phage-resistant mutants. Supplementary Figure 3: Additional SEM images of A. baumannii surface. Supplementary Figure 4: ΦFG02 and ΦCO01 are effective against A. baumannii in vivo. Supplementary Materials. Supplementary Table 1: Raw data from antibiotic sensitivity assays. Supplementary Table 2: Strains and plasmids used in this study. Supplementary Table 3: Genome assembly sources for the phylogenetic analysis of A. baumannii strains. Supplementary Table 4: Primers used in the genetic engineering of A. baumannii strains. Supplementary references.
Supplementary Data 1
Statistical source data for supplementary figures.
Source data
Source Data Fig. 1
Statistical source data for Fig. 1.
Source Data Fig. 2
Statistical source data for Fig. 2.
Rights and permissions
About this article
Cite this article
Gordillo Altamirano, F., Forsyth, J.H., Patwa, R. et al. Bacteriophage-resistant Acinetobacter baumannii are resensitized to antimicrobials. Nat Microbiol 6, 157–161 (2021). https://doi.org/10.1038/s41564-020-00830-7
Received:
Accepted:
Published:
Issue date:
DOI: https://doi.org/10.1038/s41564-020-00830-7
This article is cited by
-
Expression and application of a novel Holin Hol6A3 in phage PD6A3 of Acinetobacter baumannii
BMC Microbiology (2025)
-
Adjunctive phage therapy improves antibiotic treatment of ventilator-associated-pneumonia with Pseudomonas aeruginosa
Nature Communications (2025)
-
Rational design of a hospital-specific phage cocktail to treat Enterobacter cloacae complex infections
Nature Microbiology (2025)
-
In silico characterization of defense system hotspots in Acinetobacter spp.
Communications Biology (2025)
-
Intestinal crypt microbiota modulates intestinal stem cell turnover and tumorigenesis via indole acetic acid
Nature Microbiology (2025)